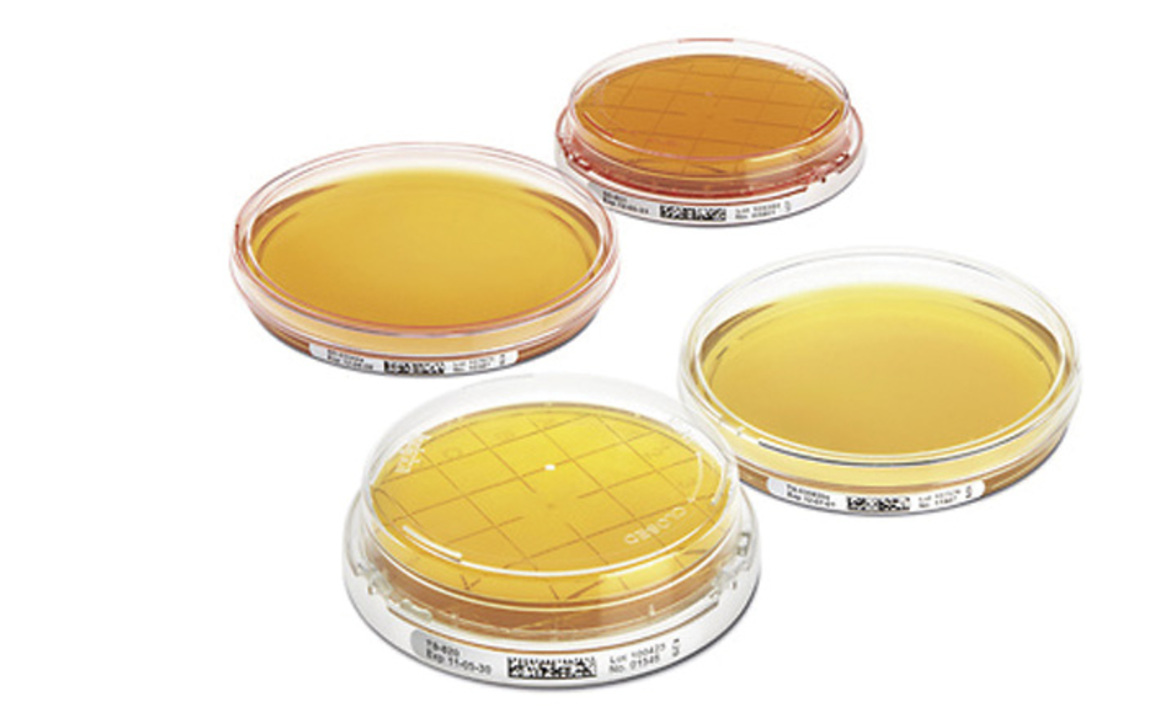
Влияние предварительного хранения проб окружающей среды на результаты подсчета микроорганизмов

Данное исследование показало, что не было обнаружено влияния на скорость роста отобранных микроорганизмов Staphylococcus aureus, Kocuria rizophila, Staphylococcus epidermidis, Propionibacterium acnes, Corynebacterium striatum, Escherichia coli и Penicillium commune, когда они подвергались различным условиям предварительного хранения до стандартной инкубации. Все показатели восстановления роста составляли от 70% до 200%.
Данные, представленные в данном исследовании показали, что не было обнаружено влияния на рост образцов, если они хранились при комнатной температуре до 18 часов или помещались в прохладное хранилище на срок до 6 часов. Несколько сниженная скорость восстановления была получена для образцов, которые предварительно хранились более 6 часов при прохладной температуре до инкубации. Хранение при комнатной температуре после отбора проб и до официальной инкубации представляется предпочтительным выбором, так как эта температура уже поддерживает рост различных микроорганизмов. Но, с другой стороны, наличие форм может нести в себе риск чрезмерного роста при длительном хранении при комнатной температуре.
Небольшая разница между исследованием прямого посева (часть I) и исследованием in situ (часть II) для проверки предварительного хранения в течение 16-18 часов при 4-8°C может быть объяснена различным составом микрофлоры in situ. Кроме того, микроорганизмы из окружающей среды могут быть повреждены в результате высыхания.
Для проверки этой разницы потребуются дополнительные исследования.